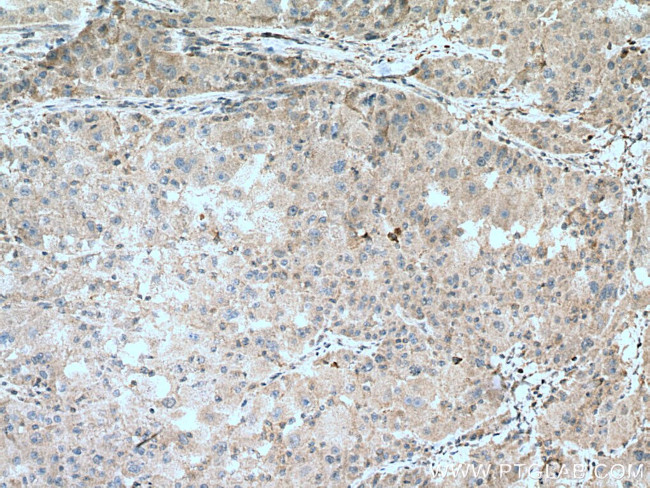
ZBP1 Antibody in Immunohistochemistry (Paraffin) (IHC (P))

Search
Proteintech
ZBP1 Polyclonal Antibody
{{$productOrderCtrl.translations['antibody.pdp.commerceCard.promotion.promotions']}}
{{$productOrderCtrl.translations['antibody.pdp.commerceCard.promotion.viewpromo']}}
{{$productOrderCtrl.translations['antibody.pdp.commerceCard.promotion.promocode']}}: {{promo.promoCode}} {{promo.promoTitle}} {{promo.promoDescription}}. {{$productOrderCtrl.translations['antibody.pdp.commerceCard.promotion.learnmore']}}
产品信息
13285-1-AP
种属反应
已发表种属
宿主/亚型
分类
类型
抗原
偶联物
形式
浓度
规格
纯化类型
保存液
内含物
保存条件
运输条件
产品详细信息
Immunogen sequence: MAQAPADPG REGHLEQRIL QVLTEAGSPV KLAQLVKECQ APKRELNQVL YRMKKELKVS LTSPATWCLG GTDPEGEGPA ELALSSPGNC HPGEAGLTLQ GASWQWTSTD LSLGSNLNSA TWELTGFLSL CLGFFFWLME LTAGLLGRGC (1-149 aa encoded by BC028218)
靶标信息
Z-DNA binding protein 1 (ZBP1) belongs to a family of proteins that contain the Zalpha domain which binds specifically to left-handed Z-DNA and Z-RNA. ZBP1 was initially identified as a novel gene that was up-regulated in activated macrophages in mice bearing ascites tumors, suggesting that is may play a role in processes such as host response in neoplasia. More recent reports indicate that the cytosolic ZBP1 has can act like the toll-like receptor TLR9 by detecting cytosolic double-stranded (ds) DNA and trigger induction of type I interferon and other innate immune responses. It is thought that the binding of ZBP1 to dsDNA enhances its association with innate immune response proteins such as the IRF3 transcription factor and the serine/threonine kinase TBK1 (also known as NAK). Multiple isoforms of ZBP1 are known to exist.
仅用于科研。不用于诊断过程。未经明确授权不得转售。
生物信息学
蛋白别名: DAI; DNA-dependent activator of IFN-regulatory factors; DNA-dependent activator of IRFs; RP4-718J7.1; Tumor stroma and activated macrophage protein DLM-1; unnamed protein product; Z-DNA-binding protein 1
基因别名: C20orf183; DAI; DLM-1; DLM1; ZBP1
UniProt ID: (Human) Q9H171
Entrez Gene ID: (Human) 81030